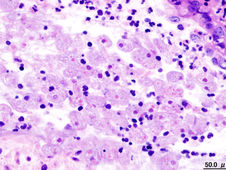

top of page



Dengue-Fieber
Das Dengue-Fieber ist eine von Stechmücken übertragene Virusinfektion, die Fieber, allgemeine Körperschmerzen und bei einer schweren...
MSD MANUAL
19. Jan. 2021


Cholera - Darminfektion
Cholera ist eine schwere Darminfektion mit starkem Durchfall, die von dem gramnegativen Bakterium Vibrio cholerae hervorgerufen wird und...
MSD MANUAL
19. Jan. 2021


Parasiteninfektion - Schistosomiasis (Bilharziose)
Schistosomiasis ist eine Infektion, die von bestimmten Plattwürmern beziehungsweise Saugwürmern ausgelöst wird, die Schistosomen oder...
MSD MANUAL
19. Jan. 2021

Amöbenruhr
Amöbenruhr ist eine Infektion des Dickdarms und manchmal der Leber und anderer Organe, die vom einzelligen Parasiten Entamoeba...
MSD MANUAL
19. Jan. 2021


AIDS HIV - Immunschwächevirus-Infektion
Eine Infektion mit dem humanen Immundefizienz-Virus (HIV) ist eine Virusinfektion, die schrittweise bestimmte weiße Blutkörperchen...
MSD MANUAL
19. Jan. 2021


Pneumokokken Infektionen
Pneumokokken-Infektionen werden durch das grampositive kugelförmige Bakterium, (siehe Pneumokokkendazu; Wie Bakterien sich entwickeln),...
MSD MANUAL
19. Jan. 2021


Scharlach und Rachenentzündung - Streptokokken-Infektionen
Streptokokken-Infektionen werden durch mehrere Streptococcus-Arten hervorgerufen. Diese grampositiven kugelförmigen Bakterien, (siehe...
MSD MANUAL
19. Jan. 2021


Haemophilus influenza b - Infektionen
Haemophilus influenzae ist ein gramnegatives Bakterium, das eine Infektion der Atemwege hervorrufen und sich weiter auf andere Organe...
MSD MANUAL
19. Jan. 2021


Drei-Tage-Fieber - Exanthema subitum, Roseola infantum
Das Drei-Tage-Fieber ist eine Virusinfektion, die Säuglinge und Kleinkinder befällt und hohes Fieber gefolgt von einem Ausschlag...
MSD MANUAL
19. Jan. 2021


Hand-Fuß-Mund - Krankheit
Bei der Hand-Fuß-Mund-Krankheit handelt es sich um eine Enterovirusinfektion, die vor allem bei kleinen Kindern Fieber und einen...
MSD MANUAL
19. Jan. 2021


Keuchhusten - Pertussis
Keuchhusten ist eine hoch ansteckende Infekt Hinweis der medinout-Redaktion: Die Inhalte des MSD Manuals für Patienten unterliegen...
MSD MANUAL
19. Jan. 2021


Parasiteninfektion - Trichinose
Trichinose ist eine Infektion, die von dem Fadenwurm Trichinella spiralis oder einer anderen Trichinellen-Art ausgelöst wird. Symptome...
MSD MANUAL
15. Dez. 2020


Geschlechtskrankheit - Syphilis
Syphilis ist eine sexuell übertragbare Krankheit, die durch das Bakterium Treponema pallidum verursacht wird. Die Infektion kann in drei...
MSD MANUAL
15. Dez. 2020


Schlafkrankheit - Afrikanische Trypanosomiasis
Die afrikanische Schlafkrankheit ist eine Infektion, die von dem Einzeller Trypanosoma brucei gambiense oder Trypanosoma brucei...
MSD MANUAL
13. Dez. 2020
bottom of page